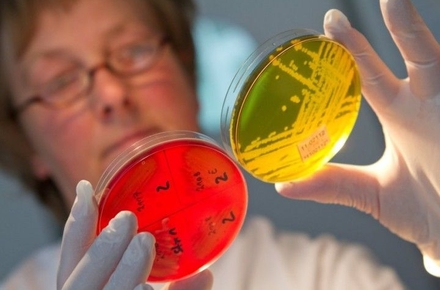

У Житомирській області значно ускладнилася епідемічна ситуація із захворюваністю населення на гострі кишкові інфекції.
Про це Житомир.info повідомив Житомирський обласний медичний центр здоров’я та спортивної медицини.
«Так, якщо упродовж 2015 року зареєстровано 4 спалахи кишкових інфекцій, то лише за І півріччя поточного року їх вже зареєстровано 6 із загальною кількістю захворілих – 43, у тому числі – 18 дітей. Побутові спалахи сальмонельозу зареєстровані у містах Малині, Бердичеві та Ружинському районі. Спалах харчової токсикоінфекції зареєстрований серед дітей дитячого дошкільного закладу в с. Кирдани Овруцького району. Спалах вірусного гепатиту А виявлений серед дітей ДНЗ № 27 м. Житомира. Ще один спалах вірусного гепатиту зареєстрований серед жителів с. Садки Житомирського району», - інформує центр здоров’я.
Основними причинами захворювання фахівці називають залучення до приготування страв випадкових осіб, не обізнаних з елементарними правилами особистої гігієни, порушення технологій приготування їжі, зберігання харчових продуктів в антисанітарних умовах, без належного температурного режиму, вживання швидкопсувних продуктів. Факторами передачі інфекції найчастіше стають готові страви, молоко і молочні продукти, кондитерські вироби, які готуються «із запасом», що призводить до накопичення у продуктах збудників інфекційних захворювань.
«За статистикою, кишкові інфекції можна віднести до сезонних захворювань, пік яких припадає на літній період. Причин такої сезонності декілька:
влітку ми частіше п'ємо некип'ячену воду з-під крана і з природніх джерел;
влітку ми частіше споживаємо свіжі овочі і фрукти, які не завжди ретельно вимиті і знезаражені;
влітку харчові продукти (особливо м'ясо, молоко, риба) псуються швидше, хоча ознаки псування можуть бути практично непомітні;
влітку з'являється велика кількість комах – переносників інфекції (доведено, наприклад, що на тілі однієї мухи знаходиться до 10 мільйонів бактерій! Залишається тільки гадати, скільки з них хвороботворних);
влітку ми п'ємо більше води, яка розбавляє шлунковий сік, послаблюючи його захисну дію.
Правила профілактики можуть здатися занадто очевидними, тим не менш, раз кишкові інфекції атакують, значить, профілактика не настільки ефективна, якою могла б бути. Отже, щоб уникнути кишкових інфекцій:
мийте руки перед їжею;
в літній період утримайтеся від вживання кондитерських виробів з кремом, приготовленим на свіжих яйцях;
зберігайте сире м'ясо і рибу окремо від готових страв у холодильнику;
ретельно промивайте фрукти, овочі, зелень (щоб позбутися від непомітних оку забруднень, зелень краще замочити на 5-7 хвилин у слабосолоному розчині);
салати зі свіжих овочів зберігайте не більше кількох годин, намагайтеся вживати тільки свіжоприготовлену їжу;
при покупці м'ясних і молочних продуктів віддавайте перевагу фабричній упаковці, обов'язково переконайтеся в терміні придатності;
пийте тільки кип'ячену воду або «мінералку», придбану в добре відомих магазинах», - радять в обласному центрі здоров’я.
Як повідомляв Житомир.info, у червні 2016 року в смт Ружин Житомирської області після святкування весілля до лікарні госпіталізували 11 осіб. Батьки наречених, на весіллі яких отруїлися гості, відмовлялися надати СЕС перелік запрошених гостей та меню.
























